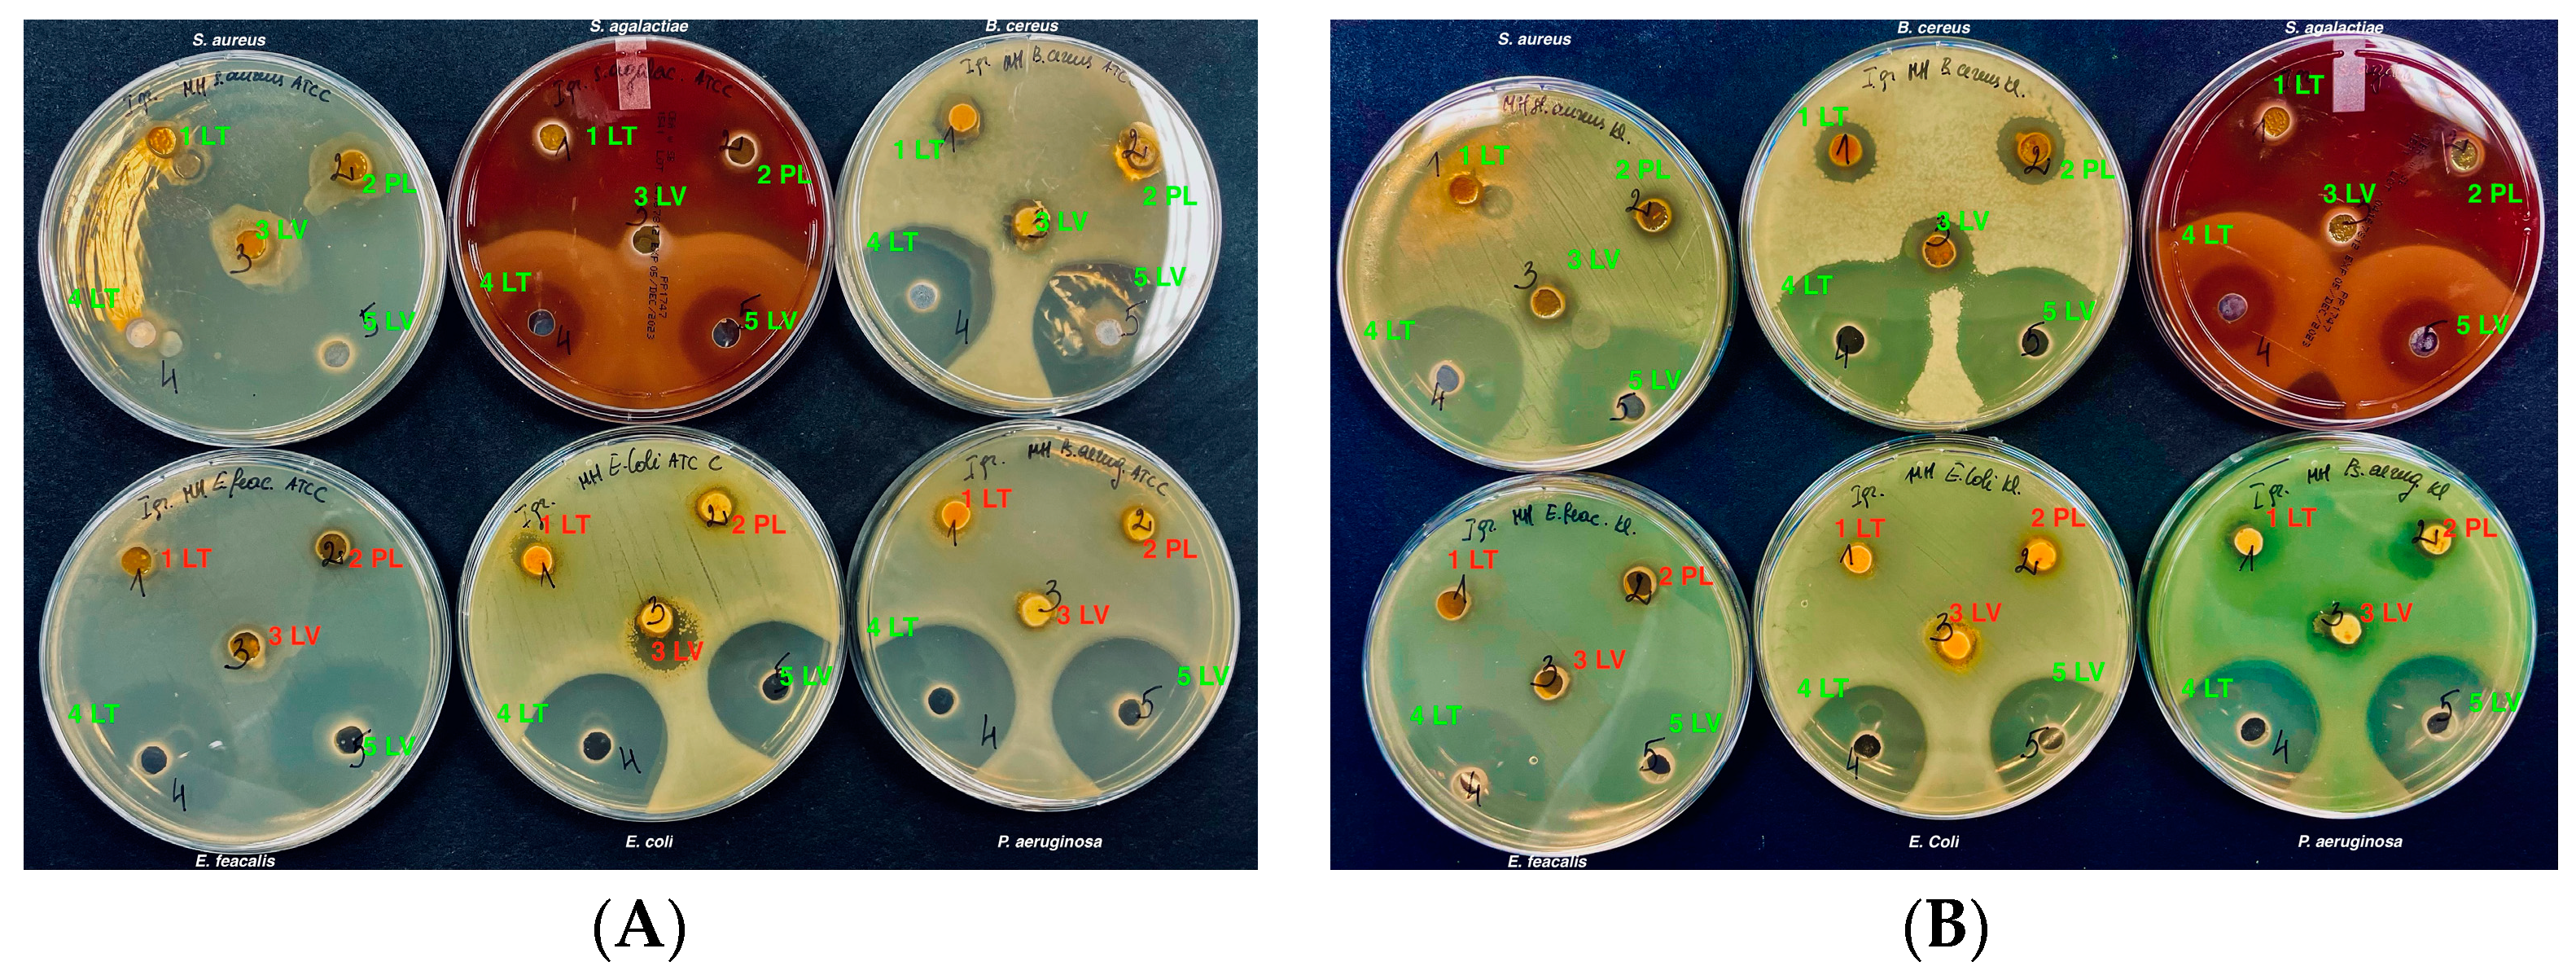
Vetsci 11 00375 g004
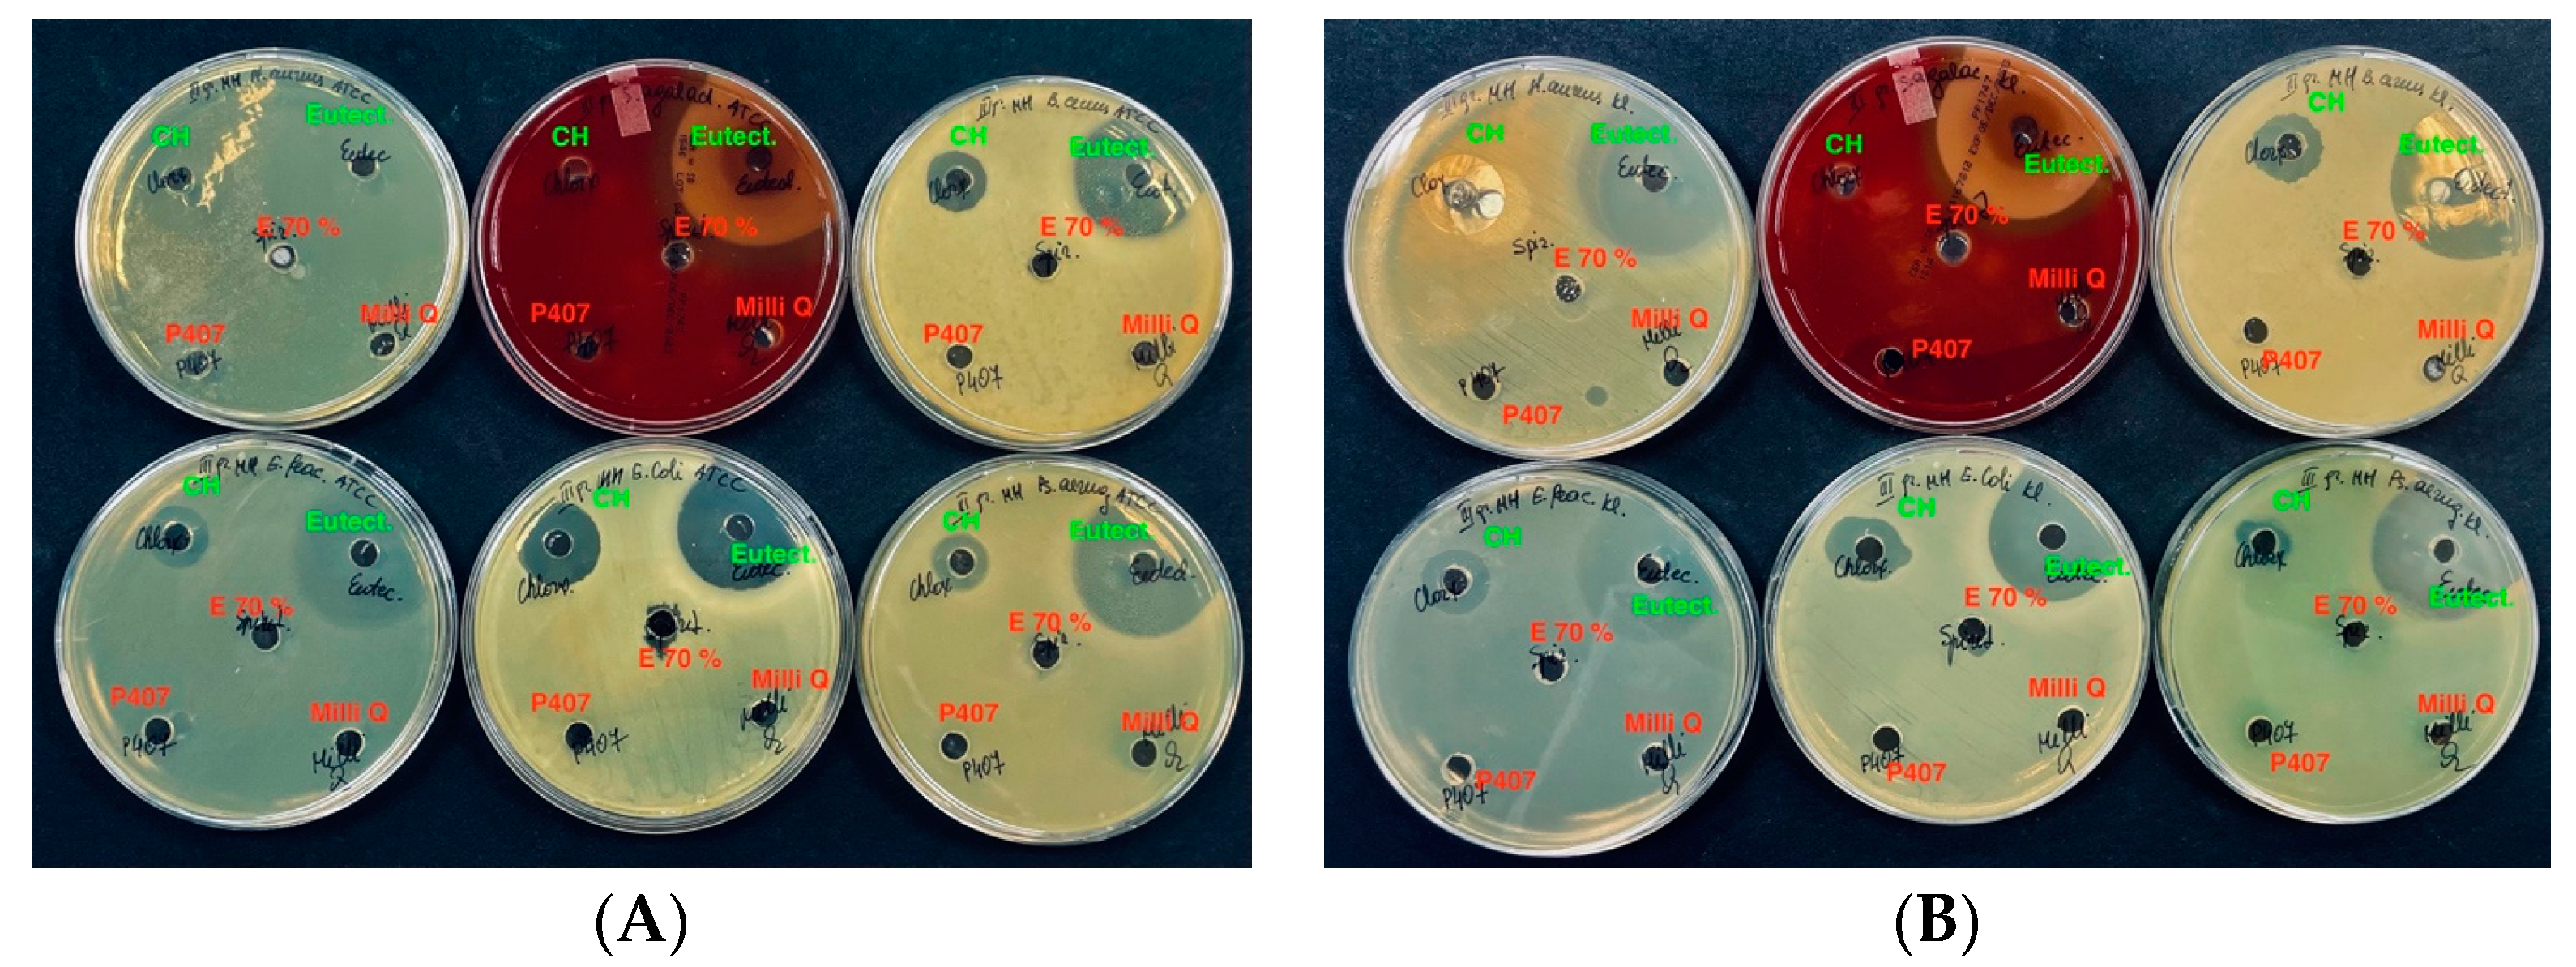
Vetsci 11 00375 g007

The Comparative Study of the Antioxidant and Antibacterial Effects of Propolis Extracts in Veterinary Medicine
Abstract
Simple Summary
Abstract
1. Introduction
2. Materials and Methods
2.1. Propolis Extraction
2.2. Ethanolic Propolis Extracts Preparation
2.3. DES Propolis Extracts Preparation
2.4. Polymeric Propolis Extracts Preparation
2.5. HPLC Analysis
2.6. Antioxidant Activity in DPPH
2.7. Antimicrobial Activity In Vitro
2.8. Minimum Inhibitory Concentration
2.9. Statistical Analysis
3. Results
3.1. HPLC Analysis of Active Compounds
3.2. Antioxidant Activity In Vitro
3.3. Determination of Antimicrobial Activity
3.4. Minimum Inhibitory Concentration
4. Discussion
5. Conclusions
Author Contributions
Funding
Institutional Review Board Statement
Informed Consent Statement
Data Availability Statement
Conflicts of Interest
References
- Patridge, E.; Gareiss, P.; Kinch, M.S.; Hoyer, D. An analysis of FDA-approved drugs: Natural products and their derivatives. Drug Discov. Today 2016, 21, 204–207. [Google Scholar] [CrossRef] [PubMed]
- Cui, C.Y.; Li, X.J.; Chen, C.; Wu, X.T.; He, Q.; Jia, Q.L.; Zhang, X.J.; Lin, Z.Y.; Li, C.; Fang, L.X.; et al. Comprehensive analysis of plasmid-mediated tet(X4)-positive Escherichia coli isolates from clinical settings revealed a high correlation with animals and environments-derived strains. Sci. Total Environ. 2022, 806, 150687. [Google Scholar] [CrossRef]
- He, T.; Wang, R.; Liu, D.J.; Walsh, T.R.; Zhang, R.; Lv, Y.; Ke, Y.B.; Ji, Q.J.; Wei, R.C.; Liu, Z.H.; et al. Emergence of plasmid-mediated high-level tigecycline resistance genes in animals and humans. Nat. Microbiol. 2019, 4, 1450–1456. [Google Scholar] [CrossRef]
- Li, Y.; Sun, X.R.; Xiao, X.; Wang, Z.Q.; Li, R.C. Global distribution and genomic characteristics of tet(X)-positive Escherichia coli among humans, animals, and the environment. Sci. Total Environ. 2023, 887, 164148. [Google Scholar] [CrossRef]
- Kuralkar, P.; Kuralkar, S.V. Role of herbal products in animal production—An updated review. J. Ethnopharmacol. 2021, 278, 114246. [Google Scholar] [CrossRef]
- Smith, J.; Doe, A.; Brown, B. The Impact of Antibiotic Residues on Antimicrobial Resistance. Antibiotics 2022, 11, 123–135. [Google Scholar]
- Liao, F.; Han, C.; Deng, Q.; Zhou, Z.; Bao, T.; Zhong, M.; Tao, G.; Li, R.; Han, B.; Qiao, Y.; et al. Natural Products as Mite Control Agents in Animals: A Review. Molecules 2023, 28, 6818. [Google Scholar] [CrossRef]
- Niu, G.; Li, W. Next-generation drug discovery to combat antimicrobial resistance. Trends Biochem. Sci. 2019, 44, 961–972. [Google Scholar] [CrossRef]
- Pancu, D.F.; Scurtu, A.; Macasoi, I.G.; Marti, D.; Mioc, M.; Soica, C.; Coricovac, D.; Horhat, D.; Poenaru, M.; Dehelean, C. Antibiotics: Conventional Therapy and Natural Compounds with Antibacterial Activity—A Pharmaco-Toxicological Screening. Antibiotics 2021, 10, 401. [Google Scholar] [CrossRef] [PubMed]
- Rizzo, A.; Piccinno, M.; Lillo, E.; Carbonari, A.; Jirillo, F.; Sciorsci, R.L. Antimicrobial Resistance and Current Alternatives in Veterinary Practice: A Review. Curr. Pharm. Des. 2023, 29, 312–322. [Google Scholar] [PubMed]
- Rahman, M.M.; Rahaman, M.S.; Islam, M.R.; Rahman, F.; Mithi, F.M.; Alqahtani, T.; Almikhlafi, M.A.; Alghamdi, S.Q.; Alruwaili, A.S.; Hossain, M.S.; et al. Role of Phenolic Compounds in Human Disease: Current Knowledge and Future Prospects. Molecules 2022, 27, 233. [Google Scholar] [CrossRef]
- Graf, B.A.; Millbury, P.E.; Blumberg, J.B. Flavonols, flavones, flavanones, and human health: Epidemiological evidence. J. Med. Food 2005, 8, 281–290. [Google Scholar] [CrossRef]
- Arts, I.C.W.; Hollman, P.C.H. Polyphenols and disease risk in epidemiologic studies. Am. J. Clin. Nutr. 2005, 81, 317–325. [Google Scholar] [CrossRef]
- Farooqui, T. Beneficial effects of propolis he human health and neurological diseases. Front. Biosci. 2012, 4, 779. [Google Scholar]
- Wang, K.; Zhang, J.; Ping, S.; Ma, Q.; Chen, X.; Xuan, H.; Shi, J.; Zhang, C.; Hu, F. Anti-inflammatory effects of ethanol extracts of Chinese propolis and buds from poplar (Populus canadensis). J. Ethnopharmacol. 2014, 155, 300–311. [Google Scholar] [CrossRef]
- Peng, S.; Wei, P.; Lu, Q.; Liu, R.; Ding, Y.; Zhang, J. Beneficial Effects of poplar Buds on Hyperglycemia, Dyslipidemia, Oxidative Stress, and Inflammation in Streptozotocin-Induced Type-2 Diabetes. J. Immunol. Res. 2018, 2018, 7245956. [Google Scholar] [CrossRef] [PubMed]
- Abd Rashid, N.; Mohammed, S.N.; Syed Abd Halim, S.A.; Ghafar, N.A.; Abdul Jalil, N.A. Therapeutic Potential of Honey and Propolis on Ocular Disease. Pharmaceuticals 2022, 15, 1419. [Google Scholar] [CrossRef]
- El Adham, E.C.; Hassan, A.I.; Dawoud, M.M.A. Evaluating the Role of Propolis and Bee Venom on the Oxidative Stress Induced by Gamma Rays in Rats. Sci. Rep. 2022, 12, 2656. [Google Scholar] [CrossRef] [PubMed]
- Kurek-Górecka, A.; Rzepecka-Stojko, A.; Górecki, M.; Stojko, J.; Sosada, M.; Swierczek-Zieba, G. Structure and antioxidant activity of polyphenols derived from propolis. Molecules 2014, 19, 78–101. [Google Scholar] [CrossRef]
- Pang, Z.; Chen, J.; Wang, T.; Gao, C.; Li, Z.; Guo, L.; Xu, J.; Cheng, Y. Linking Plant Secondary Metabolites and Plant Microbiomes: A Review. Front. Plant Sci. 2021, 12, 300. [Google Scholar] [CrossRef]
- Stanciauskaite, M.; Marksa, M.; Ivanauskas, L.; Perminaite, K.; Ramanauskiene, K. Ophthalmic In Situ Gels with Balsam Poplar Buds Extract: Formulation, Rheological Characterization, and Quality Evaluation. Pharmaceuticals 2021, 13, 953. [Google Scholar] [CrossRef] [PubMed]
- Stanciauskaite, M.; Marksa, M.; Babickaite, L.; Majiene, D.; Ramanauskiene, K. Comparison of Ethanolic and Aqueous Populus balsamifera L. Bud Extracts by Different Extraction Methods: Chemical Composition, Antioxidant and Antibacterial Activities. Pharmaceuticals 2021, 14, 1018. [Google Scholar] [CrossRef] [PubMed]
- Aboulghazi, A.; Fadil, M.; Touzani, S.; Hibaoui, L.; Hano, C.; Lyoussi, B. Phenolic Screening and Mixture Design Optimization for In Vitro Assessment of Antioxidant and Antimicrobial Activities of Honey, Propolis, and Bee Pollen. J. Food Biochem. 2024, 1, 8246224. [Google Scholar] [CrossRef]
- Stanciauskaite, M.; Marksa, M.; Rimiekene, L.; Ramanauskiene, K. Evaluation of Chemical Composition, Sun Protection Factor and Antioxidant Activity of Lithuanian Propolis and Its Plant Precursors. Plants 2022, 11, 3558. [Google Scholar] [CrossRef] [PubMed]
- Popova, M.; Giannopoulou, E.; Skalicka-Wózniak, K.; Graikou, K.; Widelski, J.; Bankova, V.; Kalofonos, H.; Sivolapenko, G.; Gaweł-Bȩben, K.; Antosiewicz, B.; et al. Characterization and biological evaluation of propolis from Poland. Molecules 2017, 22, 1159. [Google Scholar] [CrossRef]
- Kubina, R.; Kabała-Dzik, A.; Dziedzic, A.; Bielec, B.; Wojtyczka, R.D.; Bułdak, R.J.; Wyszyńska, M.; Stawiarska-Pięta, B.; Szaflarska-Stojko, E. The Ethanol Extract of Polish Propolis Exhibits Anti-Proliferative and/or Pro-Apoptotic Effect on HCT 116 Colon Cancer and Me45 Malignant Melanoma Cells In Vitro Conditions. Adv. Clin. Exp. Med. 2015, 24, 203–212. [Google Scholar] [CrossRef]
- Szliszka, E.; Krol, W. Polyphenols isolated from propolis augment TRAIL-induced apoptosis in cancer cells. Evid.-Based Complement. Altern. Med. 2013, 2013, 731940. [Google Scholar] [CrossRef] [PubMed]
- Martínez-Lorente, S.E.; Martí-Guillén, J.M.; Pedreño, M.Á.; Almagro, L.; Sabater-Jara, A.B. Higher Plant-Derived Biostimulants: Mechanisms of Action and Their Role in Mitigating Plant Abiotic Stress. Antioxidants 2024, 13, 318. [Google Scholar] [CrossRef]
- Shigenori, K.; Tomoko, H.; Tsutomu, N. Antioxidant activity of propolis of various geographic origins. Food Chem. 2004, 84, 329–339. [Google Scholar]
- Przybyłek, I.; Karpiński, T.M. Antibacterial Properties of Propolis. Molecules 2019, 24, 2047. [Google Scholar] [CrossRef]
- Smith, J.; Doe, A.; Brown, B. The Dual Mechanisms of Propolis in Antimicrobial Activity. J. Nat. Prod. 2023, 15, 100–110. [Google Scholar]
- Okińczyc, P.; Paluch, E.; Franiczek, R.; Widelski, J.; Wojtanowski, K.K.; Mroczek, T.; Krzyżanowska, B.; Skalicka-Woźniak, K.; Sroka, Z. Antimicrobial activity of Apis mellifera L. and Trigona sp. propolis from Nepal and its phytochemical analysis. Biomed. Pharmacother. 2020, 129, 110435. [Google Scholar] [CrossRef]
- Oryan, A.; Alemzadeh, E.; Moshiri, A. Potential role of propolis in wound healing: Biological properties and therapeutic activities. Biomed. Pharmacother. 2018, 98, 469–483. [Google Scholar] [CrossRef] [PubMed]
- Torres, A.; Sandjo, L.; Friedemann, M.; Tomazzoli, M.; Maraschin, M.; Mello, C.; Santos, A. Chemical characterization, antioxidant and antimicrobial activity of propolis obtained from Melipona quadrifasciata quadrifasciata and Tetragonisca angustula stingless bees. Br. J. Med Biol. Res. 2018, 51, e7118. [Google Scholar] [CrossRef]
- An, S.-H.; Ban, E.; Chung, I.-Y.; Cho, Y.-H.; Kim, A. Antimicrobial Activities of Propolis in Poloxamer Based Topical Gels. Pharmaceuticals 2021, 13, 2021. [Google Scholar] [CrossRef] [PubMed]
- Dugar, R.P.; Gajera, B.Y.; Dave, R.H. Fusion Method for Solubility and Dissolution Rate Enhancement of Ibuprofen Using Block Copolymer Poloxamer 407. AAPS PharmSciTech 2016, 17, 1428–1440. [Google Scholar] [CrossRef]
- Trusheva, B.; Petkov, H.; Chimshirova, R.; Popova, M.; Dimitrova, L.; Zaharieva, M.M.; Ilieva, Y.; Vasileva, B.; Tsvetkova, I.; Bankova, V.; et al. Insight into the influence of natural deep eutectic solvents on the extraction of phenolic compounds from poplar type propolis: Composition and in vitro biological activity. Heliyon 2024, 10, e28621. [Google Scholar] [CrossRef]
- Radošević, K.; Čanak, I.; Panić, M.; Markov, K.; Bubalo, M.C.; Frece, J.; Srček, V.G.; Redovniković, I.R. Antimicrobial, cytotoxic and antioxidative evaluation of natural deep eutectic solvents. Environ. Sci. Pollut. Res. 2018, 25, 14188–14196. [Google Scholar] [CrossRef]
- Alpat, U.; Nar, T.; Karasu, S.; Sagdic, O. Optimization of propolis extraction with natural deep eutectic solvents using central composite design. Phytochem. Lett. 2023, 58, 49–59. [Google Scholar] [CrossRef]
- Funari, C.S.; Sutton, A.T.; Carneiro, R.L.; Fraige, K.; Cavalheiro, A.J.; da Silva Bolzani, V.; Hilder, E.F.; Arrua, R.D. Natural deep eutectic solvents and aqueous solutions as an alternative extraction media for propolis. Food Res. Int. 2019, 125, 108559. [Google Scholar] [CrossRef] [PubMed]
- Yu, T.; Yang, L.; Shang, X.; Bian, S. Recovery of Cembratrien -Diols from Waste Tobacco (Nicotiana tabacum L.) Flowers by Microwave-Assisted Deep Eutectic Solvent Extraction: Optimization, Separation, and In Vitro Bioactivity. Molecules 2024, 29, 1563. [Google Scholar] [CrossRef]
- Zhang, J.; Cao, X.; Xueping, C.; Wang, K.; Shi, J.; Zhang, C.; Zheng, H.; Huoqing, Z. Comparisons of Ethanol Extracts of Chinese Propolis (Poplar Type) and poplar Gums Based he the Antioxidant Activities and Molecular Mechanism. Evid. Based Complement. Altern. Med. 2015, 2015, 307594. [Google Scholar]
- Ramanauskienė, K.; Savickas, A.; Ivanauskas, L.; Kalveniene, Z.; Kasparaviciene, G.; Banionyte, I.; Amsiejus, A.; Martirosyan, D. Analysis of Phenolic Acids in Propolis Using the High-Performance Liquid Chromatography Technique. Curr. Nutr. Food Sci. 2008, 4, 209–212. [Google Scholar] [CrossRef]
- Yim, S.H.; Nam, S.H. Physiochemical, nutritional and functional characterization of 10 different pear cultivars (Pyrus spp.). J. Appl. Bot. Food Qual. 2016, 89, 73–81. [Google Scholar]
- Babickaite, L.; Ramanauskiene, K.; Grigonis, A.; Ivaskiene, M.; Daunoras, G.; Klimiene, I.; Matusevicius, A.P. Determination of antimicrobial activity of chlorhexidine gel. Acta Pol. Pharm. 2016, 73, 1623–1630. [Google Scholar]
- Uchil, R.R.; Kohli, G.S.; Katekhaye, V.M.; Swami, O.C. Strategies to combat antimicrobial resistance. J. Clin. Diagn. Res. 2014, 8, ME01–ME04. [Google Scholar]
- Hobson, C.; Chan, A.N.; Wright, G.D. The Antibiotic Resistome: A Guide for the Discovery of Natural Products as Antimicrobial Agents. Chem. Rev. 2021, 121, 3464–3494. [Google Scholar] [CrossRef]
- Kubkomawa, H.I.; Nafarnda, D.W.; Tizhe, M.A.; Daniel, T.K.; Shua, N.J.; Ugwu, C.C.; Opara, M.N.; Neils, J.S.; Okoli, I.C. Ethno-veterinary health management practices amongst livestock producers in Africa: A review. Adv. Agric. Sci. 2020, 6, 252–257. [Google Scholar]
- Wynn, S.; Fougère, B. Clinical practice: Getting started. In Veterinary Herbal Medicine; Wynn, S., Fougère, B., Eds.; Elsevier: St. Louis, MO, USA, 2006; pp. 453–457. [Google Scholar]
- Barth, S.A.; Preussger, D.; Pietschmann, J.; Feßler, A.T.; Heller, M.; Herbst, W.; Schnee, C.; Schwarz, S.; Kloss, F.; Berens, C.; et al. In Vitro Antibacterial Activity of Microbial Natural Products against Bacterial Pathogens of Veterinary and Zoonotic Relevance. Antibiotics 2024, 13, 135. [Google Scholar] [CrossRef]
- Balcão, V.M.; Belline, B.G.; Silva, E.C.; Almeida, P.F.F.B.; Baldo, D.; Amorim, L.R.P.; Oliveira Júnior, J.M.; Vila, M.M.D.C.; Del Fiol, F.S. Isolation and Molecular Characterization of Two Novel Lytic Bacteriophages for the Biocontrol of Escherichia coli in Uterine Infections: In Vitro and Ex Vivo Preliminary Studies in Veterinary Medicine. Pharmaceutics 2022, 14, 2344. [Google Scholar] [CrossRef] [PubMed]
- Meroni, G.; Cardin, E.; Rendina, C.; Millar, V.R.H.; Filipe, J.F.S.; Martino, P.A. In Vitro Efficacy of Essential Oils from Melaleuca Alternifolia and Rosmarinus Officinalis, Manuka Honey-Based Gel, and Propolis as Antibacterial Agents against Canine Staphylococcus pseudintermedius Strains. Antibiotics 2020, 9, 344. [Google Scholar] [CrossRef] [PubMed]
- Sheppard, J.G.; McAleer, J.P.; Saralkar, P.; Geldenhuys, W.J.; Long, T.E. Allicin-Inspired Pyridyl Disulfides as Antimicrobial Agents for Multidrug-Resistant Staphylococcus Aureus. Eur. J. Med. Chem. 2018, 143, 1185–1195. [Google Scholar] [CrossRef]
- Cui, H.; Zhang, C.; Su, K.; Fan, T.; Chen, L.; Yang, Z.; Zhang, M.; Li, J.; Zhang, Y.; Liu, J. Oregano Essential Oil in Livestock and Veterinary Medicine. Animals 2024, 14, 1532. [Google Scholar] [CrossRef]
- Siddique, A.; Azim, S.; Ali, A.; Adnan, F.; Arif, M.; Imran, M.; Ganda, E.; Rahman, A. Lactobacillus reuteri and Enterococcus faecium from Poultry Gut Reduce Mucin Adhesion and Biofilm Formation of Cephalosporin and Fluoroquinolone-Resistant Salmonella enterica. Animals 2021, 11, 3435. [Google Scholar] [CrossRef] [PubMed]
- Romero, B.; Susperregui, J.; Sahagún, A.M.; Diez, M.J.; Fernández, N.; García, J.J.; López, C.; Sierra, M.; Díez, R. Use of medicinal plants by veterinary practitioners in Spain: A cross-sectional survey. Front. Vet. Sci. 2022, 9, 1060738. [Google Scholar] [CrossRef]
- Giral, T.; Hugues, B.; Soto, C.J. Suspensión oftálmica de propóleos-R: Una alternativa en el tratamiento de las oftalmopatias en animales afectivos. Rev. Electrónica Clínica Vet. 2007, 2, 1–6. [Google Scholar]
- Alfaris, A.A.; Abdulsamadm, R.K.; Swadm, A.A. Comparative Studies between Propolis, Dexametason and Gentamycin Treatments of Induced Corneal Ulcer in Rabbits. Iraqi J. Vet. Sci. 2009, 23, S75–S80. [Google Scholar]
- Zhang, Q.; Yang, A.; Tan, W.; Yang, W. Development, Physicochemical Properties, and Antibacterial Activity of Propolis Microcapsules. Foods 2023, 12, 3191. [Google Scholar] [CrossRef]
- Sforcin, J.M.; Bankova, V. Propolis: Is there a potential for the development of new drugs? J. Ethnopharmacol. 2011, 133, 253–260. [Google Scholar] [CrossRef]
- Woźniak, M.; Mrówczyńska, L.; Kwaśniewska-Sip, P.; Waskiewicz, A.; Nowak, P.; Ratajczak, I. Effect of the Solvent on Propolis Phenolic Profile and its Antifungal, Antioxidant, and In Vitro Cytoprotective Activity in Human Erythrocytes Under Oxidative Stress. Molecules 2020, 25, 4266. [Google Scholar] [CrossRef]
- Radošević, K.; Ćurko, N.; Gaurina Srček, V.; Cvjetko Bubalo, M.; Tomašević, M.; Kovačević Ganić, K.; Radojčić Redovniković, I. Natural Deep Eutectic Solvents as Beneficial Extractants for Enhancement of Plant Extracts Bioactivity. LWT Food Sci. Technol. 2016, 73, 45–51. [Google Scholar] [CrossRef]
- Mustafa, N.R.; Spelbos, V.S.; Witkamp, G.-J.; Verpoorte, R.; Choi, Y.H. Solubility and Stability of Some Pharmaceuticals in Natural Deep Eutectic Solvents-Based Formulations. Molecules 2021, 26, 2645. [Google Scholar] [CrossRef]
- Bouchelaghem, S. Propolis characterization and antimicrobial activities against Staphylococcus aureus and Candida albicans: A review. Saudi J. Biol. Sci. 2022, 29, 1936–1946. [Google Scholar] [CrossRef]
- Wojtacka, J. Propolis Against Pharmacological Interventions in Bees. Molecules 2022, 27, 4914. [Google Scholar] [CrossRef]
- Stančiauskaitė, M.; Marksa, M.; Liaudanskas, M.; Ivanauskas, L.; Ivaskienė, M.; Ramanauskienė, K. Poplar buds (Populus balsamifera L., Populus nigra L.) and Lithuanian propolis extracts: Comparison of their composition and biological activity. Plants 2021, 10, 828. [Google Scholar] [CrossRef] [PubMed]
- Woźniak, M.; Sip, A.; Mrówczyńska, L.; Broniarczyk, J.; Waśkiewicz, A.; Ratajczak, I. Biological Activity and Chemical Composition of Propolis from Various Regions of Poland. Molecules 2022, 28, 141. [Google Scholar] [CrossRef]
- Kiliç, I.; Yeşiloğlu, Y. Spectroscopic Studies he the Antioxidant Activity of P-Coumaric Acid. Spectrochim. Vineg. Part A Mol. Biomol. Spectrosc. 2013, 115, 719–724. [Google Scholar] [CrossRef]
- Naman, D.R.; Dilpreet, S. A critical appraisal on ferulic acid: Biological profile, biopharmaceutical challenges and nano formulations. Health Sci. Rev. 2022, 5, 100063. [Google Scholar]
- Olatunde, A.; Aminu, M.; Ibrahim, M.A.; Tajuddeen, N.; Shuaibu, M.N. Vanillin: A food additive with multiple biological activities. Eur. J. Med. Chem. Rep. 2022, 5, 100055. [Google Scholar] [CrossRef]
- Tanner, G.; Vardar, D.O.; Aydın, S.; Aytaç, Z.; Basaran, A.A.; Basaran, N. Use of in vitro assays to assess the potential cytotoxic, genotoxic and antigenotoxic effects of vanillic and cinnamic acid. Drug Chem. Toxicol. 2016, 40, 183–190. [Google Scholar] [CrossRef] [PubMed]
- Kedar, S.B.; Singh, R.P. Genesis and development of DPPH method of antioxidant assay. J. Food Sci. Technol. 2011, 48, 412–422. [Google Scholar] [CrossRef] [PubMed]
- Rasul, A.; Millimouno, F.M.; Eltayb, W.A.; Ali, M.; Lee, J.; Li, X. Pinocembrin: A Novel Natural Compound with Versatile Pharmacological and Biological Activities. BioMed Res. Int. 2013, 2013, 379850. [Google Scholar] [CrossRef]
- Dezmirean, D.S.; Mărghita, S.L.A.; Chirila, F.; Copaciu, F.; Simonca, V.; Bobis, O.; Erler, S. Influence of geographic origin, plant source and polyphenolic substances on antimicrobial properties of propolis against human and honey bee pathogens. J. Apic. Res. 2017, 56, 588–597. [Google Scholar] [CrossRef]
- Melo, J.G.A.D.; Soares, D.M.; Santos, S.C.D. In-vitro antibacterial activity of propolis extract against periodontopathogenic bacteria: A systematic review. Rev. Port. Estomatol. Med. Dent. Cir. Maxilofac. 2024, 65, 3–14. [Google Scholar] [CrossRef]
- Vadillo-Rodríguez, V.; Fernández-Babiano, I.; Pérez-Giraldo, C.; Fernández-Calderón, M.C. Anti-Biofilm Perspectives of Propolis against Staphylococcus epidermidis Infections. Biomolecules 2024, 14, 779. [Google Scholar] [CrossRef] [PubMed]
- Dezmirean, D.S.; Paşca, C.; Moise, A.R.; Bobiş, O. Plant Sources Responsible for the Chemical Composition and Main Bioactive Properties of Poplar-Type Propolis. Plants 2020, 10, 22. [Google Scholar] [CrossRef]
- Kubiliene, L.; Laugaliene, V.; Pavilonis, A.; Maruska, A.; Majiene, D.; Barcauskaite, K.; Kubilius, R.; Kasparaviciene, G.; Savickas, A. Alternative preparation of propolis extracts: Comparison of their composition and biological activities. BMC Complement. Altern. Med. 2015, 15, 156. [Google Scholar] [CrossRef]
- Brown, E.; Wright, G. Antibacterial friend discovery in the resistance era. Nature 2016, 529, 336–343. [Google Scholar] [CrossRef]
- Jones, K.E.; Patel, N.G.; Levy, M.A.; Storeygard, A.; Balk, D.; Gittleman, J.L.; Daszak, P. Global trends in emerging infectious diseases. Nature 2008, 451, 990–993. [Google Scholar] [CrossRef]
- WHO (World Health Organization). Global Action Plan on Antimicrobial Resistance; WHO Library Cataloguing-in-Publication Data; WHO: Geneva, Switzerland, 2015. [Google Scholar]
- Betancourt, N.T.; García-Contreras, L.; Cruz Sánchez, T.A. Propolis in dogs: Clinical experiences and perspectives (A brief review). Open J. Vet. Med. 2015, 5, 53251. [Google Scholar] [CrossRef]
- Cardoso, R.L.; Maboni, F.; Machado, G.; Hartz, A.S.; Castagna de Vargas, A. Antimicrobial activity of propolis extract against Staphylococcus coagulase positive and Malassezia pachydermatis of canine otitis. Vet. Microbiol. 2010, 142, 432–434. [Google Scholar] [CrossRef] [PubMed]
- Freitas, A.S.; Cunha, A.; Oliveira, R.; Almeida-Aguiar, C. Propolis antibacterial and antioxidant synergisms with gentamicin and honey. J. Appl. Microbiol. 2022, 132, 2733–2745. [Google Scholar] [CrossRef] [PubMed]
- Probst, I.S.; Sforcin, J.M.; VLM, R.; Fernandes, A.A.H.; Fernandes Júnior, A. Antimicrobial activity of propolis and essential oils and synergism between these natural products. J. Venom. Animat. Toxins Incl. Trop. Dis. 2011, 17, 159–167. [Google Scholar] [CrossRef]
- Pobiega, K.; Kraśniewska, K.; Derewiaka, D.; Gniewosz, M. Comparison of the antimicrobial activity of propolis extracts obtained by means of various extraction methods. J. Food Sci. Technol. 2019, 56, 5386–5395. [Google Scholar] [CrossRef] [PubMed]
- Bankova, V.; Boudourova-Krasteva, G.; Popov, S.; Sforcin, J.M.; Funari, S.R.C. Seasonal variations of the chemical composition of Brazilian propolis. Apidologie 1998, 29, 361–367. [Google Scholar] [CrossRef]
- De Kraker, M.E.A.; Davey, P.G.; Grundmann, H. Mortality and Hospital Stay Associated with Resistant Staphylococcus aureus and Escherichia coli Bacteremia: Estimating the Burden of Antibiotic Resistance in Europe. PLoS Med. 2011, 8, e1001104. [Google Scholar] [CrossRef] [PubMed]
- Tzani, A.; Pitterou, I.; Divani, F.; Tsiaka, T.; Sotiroudis, G.; Zoumpoulakis, P.; Detsi, A. Green Extraction of Greek Propolis Using Natural Deep Eutectic Solvents (NADES) and Incorporation of the NADES-Extracts in Cosmetic Formulation. Sustain. Chem. 2023, 4, 8–25. [Google Scholar] [CrossRef]
- Bedair, H.M.; Samir, T.M.; Mansour, F.R. Antibacterial and antifungal activities of natural deep eutectic solvents. Appl. Microbiol. Biotechnol. 2024, 108, 198. [Google Scholar] [CrossRef] [PubMed]
- Otręba, M.; Marek, Ł.; Tyczyńska, N.; Stojko, J.; Kurek-Górecka, A.; Górecki, M.; Olczyk, P.; Rzepecka-Stojko, A. Propolis as Natural Product in the Oral Cavity Bacterial Infections Treatment: A Systematic Review. Appl. Sci. 2022, 12, 10123. [Google Scholar] [CrossRef]
- Grecka, K.; Kuś, P.M.; Okińczyc, P.; Worobo, R.W.; Walkusz, J.; Szweda, P. The Anti-Staphylococcal Potential of Ethanolic Polish Propolis Extracts. Molecules 2019, 24, 1732. [Google Scholar] [CrossRef]
- Dziedzic, A.; Kubina, R.; Wojtyczka, R.D.; Kabała-Dzik, A.; Tanasiewicz, M.; Morawiec, T. The antibacterial effect of ethanol extract of polish propolis on mutans streptococci and lactobacilli isolated from saliva. Evid. Based Complement Altern. Med. 2013, 2013, 681891. [Google Scholar] [CrossRef] [PubMed]
- Nichitoi, M.M.; Josceanu, A.M.; Isopescu, R.D.; Isopencu, G.O.; Geana, E.I.; Ciucure, C.T.; Lavric, V. Polyphenolics profile effects upon the antioxidant and antimicrobial activity of propolis extracts. Sci. Rep. 2021, 11, 20113. [Google Scholar] [CrossRef]
- Boutoub, O.; El-Guendouz, S.; Matos, I.; El Ghadraoui, L.; Costa, M.C.; Carlier, J.D.; Faleiro, M.L.; Figueiredo, A.C.; Estevinho, L.M.; Miguel, M.G. Chemical Characterization and Biological Properties Assessment of Euphorbia resinifera and Euphorbia officinarum Moroccan Propolis. Antibiotics 2024, 13, 230. [Google Scholar] [CrossRef]
- Kerek, Á.; Csanády, P.; Tuska-Szalay, B.; Kovács, L.; Jerzsele, Á. In Vitro Efficacy of Hungarian Propolis against Bacteria, Yeast, and Trichomonas gallinae Isolated from Pigeons—A Possible Antibiotic Alternative? Resources 2023, 12, 101. [Google Scholar] [CrossRef]
- Dégi, J.; Herman, V.; Igna, V.; Dégi, D.M.; Hulea, A.; Muselin, F.; Cristina, R.T. Antibacterial Activity of Romanian Propolis against Staphylococcus aureus Isolated from Dogs with Superficial Pyoderma: In Vitro Test. Vet. Sci. 2022, 9, 299. [Google Scholar] [CrossRef]
- Stepanović, S.; Antić, N.; Dakić, I.; Svabić-Vlahović, M. In vitro antimicrobial activity of propolis and synergism between propolis and antimicrobial drugs. Microbiol. Res. 2003, 158, 353–357. [Google Scholar] [CrossRef] [PubMed]
- Zulhendri, F.; Chandrasekaran, K.; Kowacz, M.; Ravalia, M.; Kripal, K.; Fearnley, J.; Perera, C.O. Antiviral, Antibacterial, Antifungal, and Antiparasitic Properties of Propolis: A Review. Foods 2021, 10, 1360. [Google Scholar] [CrossRef]
- Trusheva, B.; Petkov, H.; Popova, M.; Dimitrova, L.; Zaharieva, M.; Tsvetkova, I.; Bankova, V. “Green” approach to propolis extraction: Natural deep eutectic solvents. Comptes Rendus L’academie Bulg. Sci. 2019, 72, 897–905. [Google Scholar]
- Deegan, K.R.; Fonseca, M.S.; Oliveira, D.C.P.; Santos, L.M.; Fernandez, C.C.; Hanna, S.A.; Machado, B.A.S.; Umsza-Guez, M.A.; Meyer, R.; Portela, R.W. Susceptibility of Malassezia pachydermatis Clinical Isolates to Allopathic Antifungals and Brazilian Red, Green, and Brown Propolis Extracts. Front. Vet. Sci. 2019, 6, 460. [Google Scholar] [CrossRef]
- AL-Ani, I.; Zimmermann, S.; Reichling, J.; Wink, M. Antimicrobial Activities of European Propolis Collected from Various Geographic Origins Alone and in Combination with Antibiotics. Medicines 2018, 5, 2. [Google Scholar] [CrossRef] [PubMed]
- Jorge, R.; Furtado, N.A.J.C.; Sousa, J.P.B.; da Silva Filho, A.A.; Gregório Junior, L.E.; Martins, C.H.G.; Soares, A.E.E.; Bastos, J.K.; Cunha, W.R.; Silva, M.L.A. Brazilian Propolis: Seasonal Variation of the Prenylated p-Coumaric Acids and Antimicrobial Activity. Pharm. Biol. 2008, 46, 889–893. [Google Scholar] [CrossRef]
- Herald, P.J.; Davidson, P.M. Antibacterial activity of selected hydroxycinnamic acids. J. Food Sci. 1983, 48, 1378–1379. [Google Scholar] [CrossRef]
- Tong, S.Y.; Davis, J.S.; Eichenberger, E.; Holland, T.L.; Fowler, V.G. Staphylococcus aureus infections: Epidemiology, pathophysiology, clinical manifestations, and management. Clin. Microbiol. Rev. 2015, 28, 603–661. [Google Scholar] [CrossRef] [PubMed]
- Fuentes Esquivel, D.B.; Pérez, B.R.; Betancourt, N.T.; García Tovar, C.G.; Penieres Carrillo, J.G.; Galindo, F.H.; Flores, J.P.; Sánchez, T.A.C. In Vitro Antimycotic Activity and Structural Damage against Canine Malassezia pachydermatis Strains Caused by Mexican Stingless Bee Propolis. Vet. Sci. 2024, 11, 106. [Google Scholar] [CrossRef] [PubMed]
- Cruz Sánchez, T.A.; Estrada García, P.A.; López Zamora, C.I.; Autran Martínez, M.; Pérez Valencia, V.; Londoño Orozco, A. Use of Propolis for Tipical Treatment of Dermatophytosis in Dog. Open J. Vet. Med. 2014, 4, 239–245. [Google Scholar] [CrossRef]
- Rocha, D.; Freitas, D.S.; Magalhães, J.; Fernandes, M.; Silva, S.; Noro, J.; Ribeiro, A.; Cavaco-Paulo, A.; Martins, M.; Silva, C. NADES-Based Cork Extractives as Green Ingredients for Cosmetics and Textiles. Processes 2023, 11, 309. [Google Scholar] [CrossRef]
- Kostoglou, D.; Vass, A.; Giaouris, E. Comparative Assessment of the Antibacterial and Antibiofilm Actions of Benzalkonium Chloride, Erythromycin, and L (+)-Lactic Acid against Raw Chicken Meat Campylobacter spp. Isolates. Antibiotics 2024, 13, 201. [Google Scholar] [CrossRef]

| Solvent | Propolis | Vanillic Acid (mg/g) | Vanillin (mg/g) | Ferulic Acid (mg/g) | Cinnamon Acid (mg/g) | p-Coumaric Acid (mg/g) |
|---|---|---|---|---|---|---|
| Ethanol | 1 LT | 28.63 | 587.49 | 693.18 | 36.05 | 1506.65 |
| SD | 2.37 | 33.86 | 27.83 | 3.98 | 91.39 | |
| 2 PL | 23.16 | 463.10 | 473.59 | 21.12 | 1155.90 | |
| SD | 0.20 | 2.99 | 15.02 | 0.99 | 21.57 | |
| 3 LV | 22.23 | 574.51 | 593.26 | 38.83 | 1415.98 | |
| SD | 0.94 | 19.62 | 22.82 | 0.23 | 73.92 | |
| Eutectic | 4 LT | 19.61 | 404.78 | 315.54 | 16.29 | 954.76 |
| SD | 0.40 | 13.49 | 8.30 | 0.01 | 51.95 | |
| 5 LV | 3.19 | 141.03 | 112.79 | 7.41 | 321.13 | |
| SD | 0.19 | 0.42 | 1.62 | 0.28 | 10.44 | |
| 6 PL | 5.28 | 168.84 | 89.06 | 5.18 | 328.05 | |
| SD | 0.27 | 3.46 | 5.24 | 0.09 | 17.33 | |
| P407 | 7 LT | 5.30 | - | 6.05 | 0.49 | 14.94 |
| SD | 0.22 | - | 0.05 | 0.00 | 0.03 | |
| 8 PL | 7.26 | - | 1.48 | - | 5.34 | |
| SD | 0.40 | - | 0.08 | - | 0.37 | |
| 9 LV | 0.53 | 14.36 | 10.93 | 0.87 | 30.80 | |
| SD | 0.01 | 1.33 | 0.12 | 0.01 | 1.79 |
| Eutectic Propolis Extract | Ethanol Propolis Extract | p-Coumaric Acid | ||||
|---|---|---|---|---|---|---|
| MIC Reference Strains (µg/mL) | MIC Wild Strains (µg/mL) | MIC Reference Strains (µg/mL) | MIC Wild Strains (µg/mL) | MIC Reference Strains (µg/mL) | MIC Wild Strains (µg/mL) | |
| S. aureus | 50 | 100 | 500 | 1000 | 200 | 500 |
| S. agalactiae | 200 | 200 | 1000 | 500 | 100 | 200 |
| B. cereus | 120 | 200 | 1000 | 500 | 500 | 500 |
| E. feacalis | 500 | 500 | 1000 | 1000 | 200 | 500 |
| E.coli | 1000 | 1000 | 5000 | 5000 | 500 | 1000 |
| P. aeruginosa | 1000 | 1000 | 5000 | 5000 | 500 | 1000 |
Disclaimer/Publisher’s Note: The statements, opinions and data contained in all publications are solely those of the individual author(s) and contributor(s) and not of MDPI and/or the editor(s). MDPI and/or the editor(s) disclaim responsibility for any injury to people or property resulting from any ideas, methods, instructions or products referred to in the content. |
© 2024 by the authors. Licensee MDPI, Basel, Switzerland. This article is an open access article distributed under the terms and conditions of the Creative Commons Attribution (CC BY) license (https://creativecommons.org/licenses/by/4.0/).
Share and Cite
Svetikiene, D.; Zamokas, G.; Jokubaite, M.; Marksa, M.; Ivanauskas, L.; Babickaite, L.; Ramanauskiene, K. The Comparative Study of the Antioxidant and Antibacterial Effects of Propolis Extracts in Veterinary Medicine. Vet. Sci. 2024, 11, 375. https://doi.org/10.3390/vetsci11080375
Svetikiene D, Zamokas G, Jokubaite M, Marksa M, Ivanauskas L, Babickaite L, Ramanauskiene K. The Comparative Study of the Antioxidant and Antibacterial Effects of Propolis Extracts in Veterinary Medicine. Veterinary Sciences. 2024; 11(8):375. https://doi.org/10.3390/vetsci11080375
Chicago/Turabian StyleSvetikiene, Dovile, Gintaras Zamokas, Monika Jokubaite, Mindaugas Marksa, Liudas Ivanauskas, Lina Babickaite, and Kristina Ramanauskiene. 2024. "The Comparative Study of the Antioxidant and Antibacterial Effects of Propolis Extracts in Veterinary Medicine" Veterinary Sciences 11, no. 8: 375. https://doi.org/10.3390/vetsci11080375
APA StyleSvetikiene, D., Zamokas, G., Jokubaite, M., Marksa, M., Ivanauskas, L., Babickaite, L., & Ramanauskiene, K. (2024). The Comparative Study of the Antioxidant and Antibacterial Effects of Propolis Extracts in Veterinary Medicine. Veterinary Sciences, 11(8), 375. https://doi.org/10.3390/vetsci11080375
